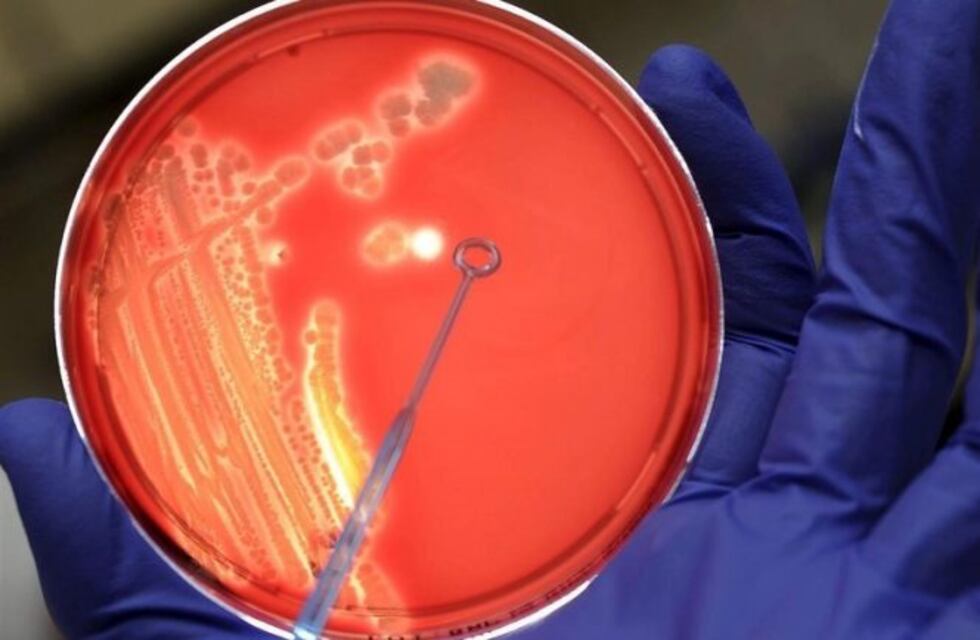
Está fuera de peligro el menor con streptococcus pyogenes en Mendoza

La Dirección General de Escuelas y el Ministerio de Salud, Desarrollo Social y Deportes confirmaron que está fuera de peligro el menor mendocino que padece streptococcus pyogenes (conocido como "estreptococo"). El pequeño estudia en la escuela Rawson, de Godoy Cruz
"Está en su casa con antibióticos, los mismos que se utilizan para la faringitis bacteriana", indicaron las fuentes y pidieron a la sociedad que no entre en pánico.
El streptococus pyogenes causa un amplio espectro de enfermedades, que van desde cuadros leves como faringitis, amigdalitis, impétigo y escarlatina, hasta infecciones invasivas graves, como meningitis, fascitis necrotizante o septicemia, que pueden provocar la muerte. Es una patología muy frecuente en pediatría" y más en esta época del año (finales del invierno y principios de la primavera), informó la Sociedad Argentina de Pediatría a través de una alerta emitida ante la demanda creciente de consultas de padres asustados.
Esta bacteria tomó relevancia nacional luego de que seis muertes en distintas partes del país. Sin embargo, en la provincia no hubo, hasta el momento, situaciones de gravedad.
En su forma más suave, esta bacteria, para la que no hay vacuna, es la causa más común de dolor de garganta de origen bacteriano.
De hecho, se estima que afecta cada año aproximadamente en todo el mundo a entre el 8% y el 15% de los niños en edad escolar, según un documento de 2014 para la Organización Mundial de la Salud sobre el estado de la investigación para el desarrollo de una vacuna.
Pero en su forma más agresiva genera una infección invasiva que penetra los tejidos del cuerpo y puede ser letal. Mata a unas 500.000 personas cada año en el mundo, informa la BBC.
Recomendaciones a seguir ante la presencia de posibles casos:
– No automedicarse, sino consultar al médico.
– Los pacientes deben cumplir con el reposo domiciliario hasta recibir el alta médica.
– Intensificar las medidas de higiene de las instalaciones donde esté o concurra la persona regularmente.
Medidas preventivas para evitar el contagio:
– Al toser o estornudar, cubrir nariz y boca con el ángulo interno del codo o con un pañuelo descartable. Desechar el pañuelo en la basura después de su uso.
– Lavarse las manos con frecuencia con agua y jabón, especialmente después de toser o estornudar.
– No tocar los ojos, nariz o boca con manos sin lavar.
– Evitar estar en contacto estrecho con personas que están enfermas.
– Mantener la higiene de superficies, particularmente en los lugares o elementos que sean de uso público.
– Airear y ventilar los ámbitos concurridos y permitir la entrada de sol, aún con temperaturas bajas.
– Limpiar y desinfectar superficies u objetos de contacto más comunes en el hogar, en el trabajo o en la escuela, especialmente cuando alguien está enfermo. Vaciar los cestos de basura las veces que sea necesario.
– Usar productos de limpieza general que utilice normalmente. Seguir siempre las instrucciones de la etiqueta de los productos.
– Proporcionar los suministros adecuados, como productos de limpieza generales registrados, guantes, toallitas desinfectantes y cestos de basura que no requieran contacto con la